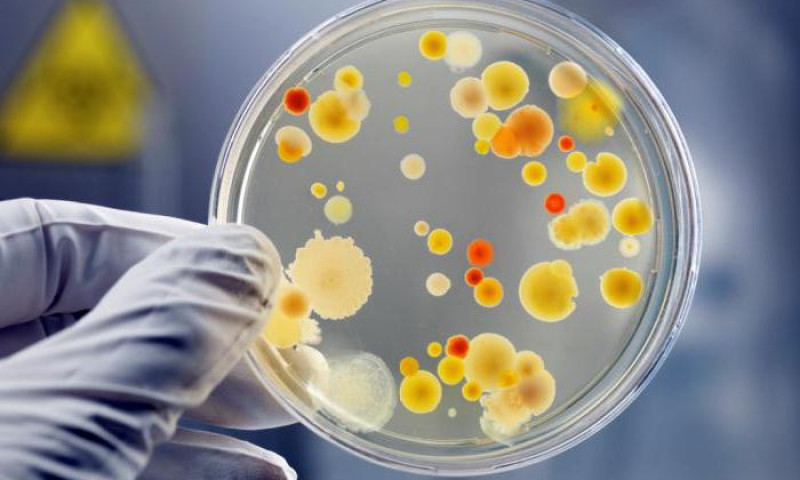

संक्रमणबाट जोगिन अपनाउनुस् यो उपाय
निद्रा हाम्रो स्वास्थ्यका लागि अति आवश्यक हुन्छ । समयमा सुतेनौँ र निद्रा पुरा भएन भने हामीलाई विभिन्न समस्याहरु हुन थाल्छ । हामिले आफ्नो खानपानका साथै व्यायाममा विशेष ध्यान दिँदा दिँदै पनि अस्वस्थ हुने गर्छौँ । खानपान र व्यायामका बाबजुद हामी अस्वस्थ हुनुको कारण हो , निद्रा पुरा नहुनु ।
हालै गरिएको एक अध्ययनका अनुसार, निद्राको सिधा सम्बन्ध हाम्रो इम्यून सिस्टमसँग हुन्छ । नेशनल हेल्थ एन्ड न्यूट्रीशन एक्जामिनेशन द्वारा गरिएको एक सर्वेमा, इम्यून सिस्टमको सक्रियता तपाईँ कति घण्टा सुत्नु हुन्छ त्यसमा निर्भर हुन्छ ।
उक्त अध्ययनका लागि अध्ययनकर्ताहरुले २२ हजार ७ सय २६ वयस्क व्यक्तिमाथि सन् २००५ देखि २०१५ सम्म परीक्षण गरेको थियो । अध्ययनबाट जो व्यक्ति कम सुत्छन् उनको इम्यून सिस्टम अर्थात् प्रतिरक्षा प्रणली कमजोर हुन्छ र उनलाई रुघाखोकी, ज्वरो जस्ता रोगले सजिलै समात्ने गरेको पत्ता लागेको छ । त्यतिमात्र नभई निद्रा पुरा भएन भने टाउको दुख्ने, आँखा पोल्ने समस्या पनि हुन्छ ।
विशेषज्ञहरुका अनुसार, जो व्यक्ति पाँच घण्टाभन्दा कम सुत्ने गर्छन् उनमा रुघाखोकी र ज्वरो लाग्ने सम्भावना २० प्रतिशत सम्म बढी हुन्छ भने ७ घण्टा सम्म सुत्ने व्यक्तिमा संक्रमणको खतरा नगन्य मात्रामा हुन्छ । साथै तपाईं कति घण्टा सम्म सुत्नु हुन्छ त्यसले पनि तपाईँको स्वास्थ्यमा प्रभाव पार्छ भन्ने कुरा अध्ययनबाट पत्ता लागेको छ ।
अध्ययनकर्ता मध्येका प्रमुख एरिक प्रथेरका अनुसार, रोग प्रतिरक्षा प्रणालीलाई ठिक बनाई राख्न र प्रतिरक्षा प्रणालीले राम्रो सँग काम गरिरहनका लागि चाहिने जति निद्रा पुरा गर्नु पर्छ ।
(एजेन्सीको सहयोगमा)